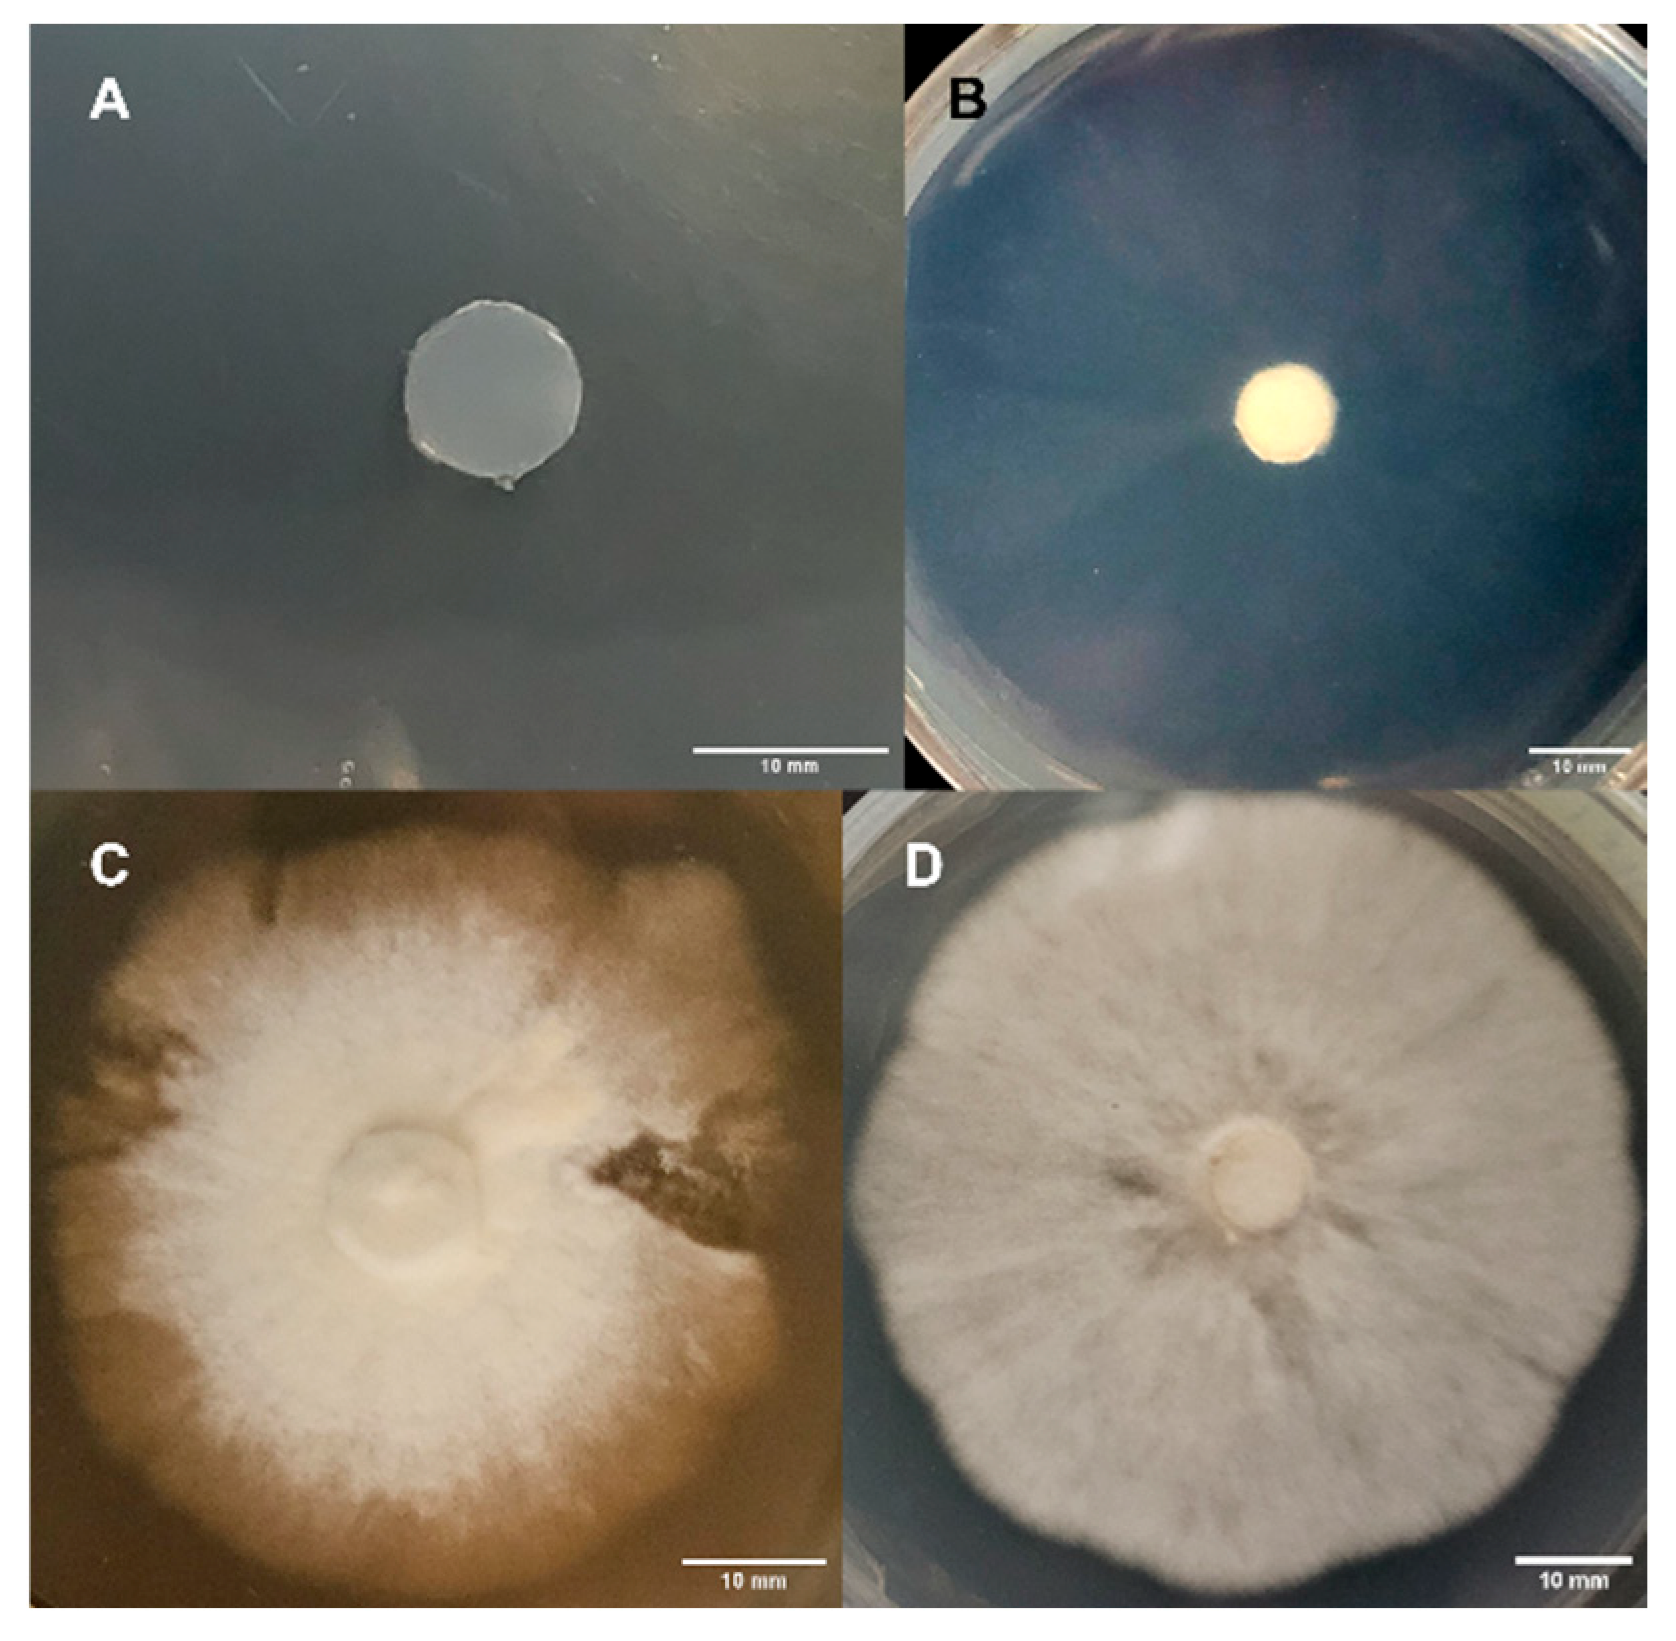
Jof 11 00450 g002
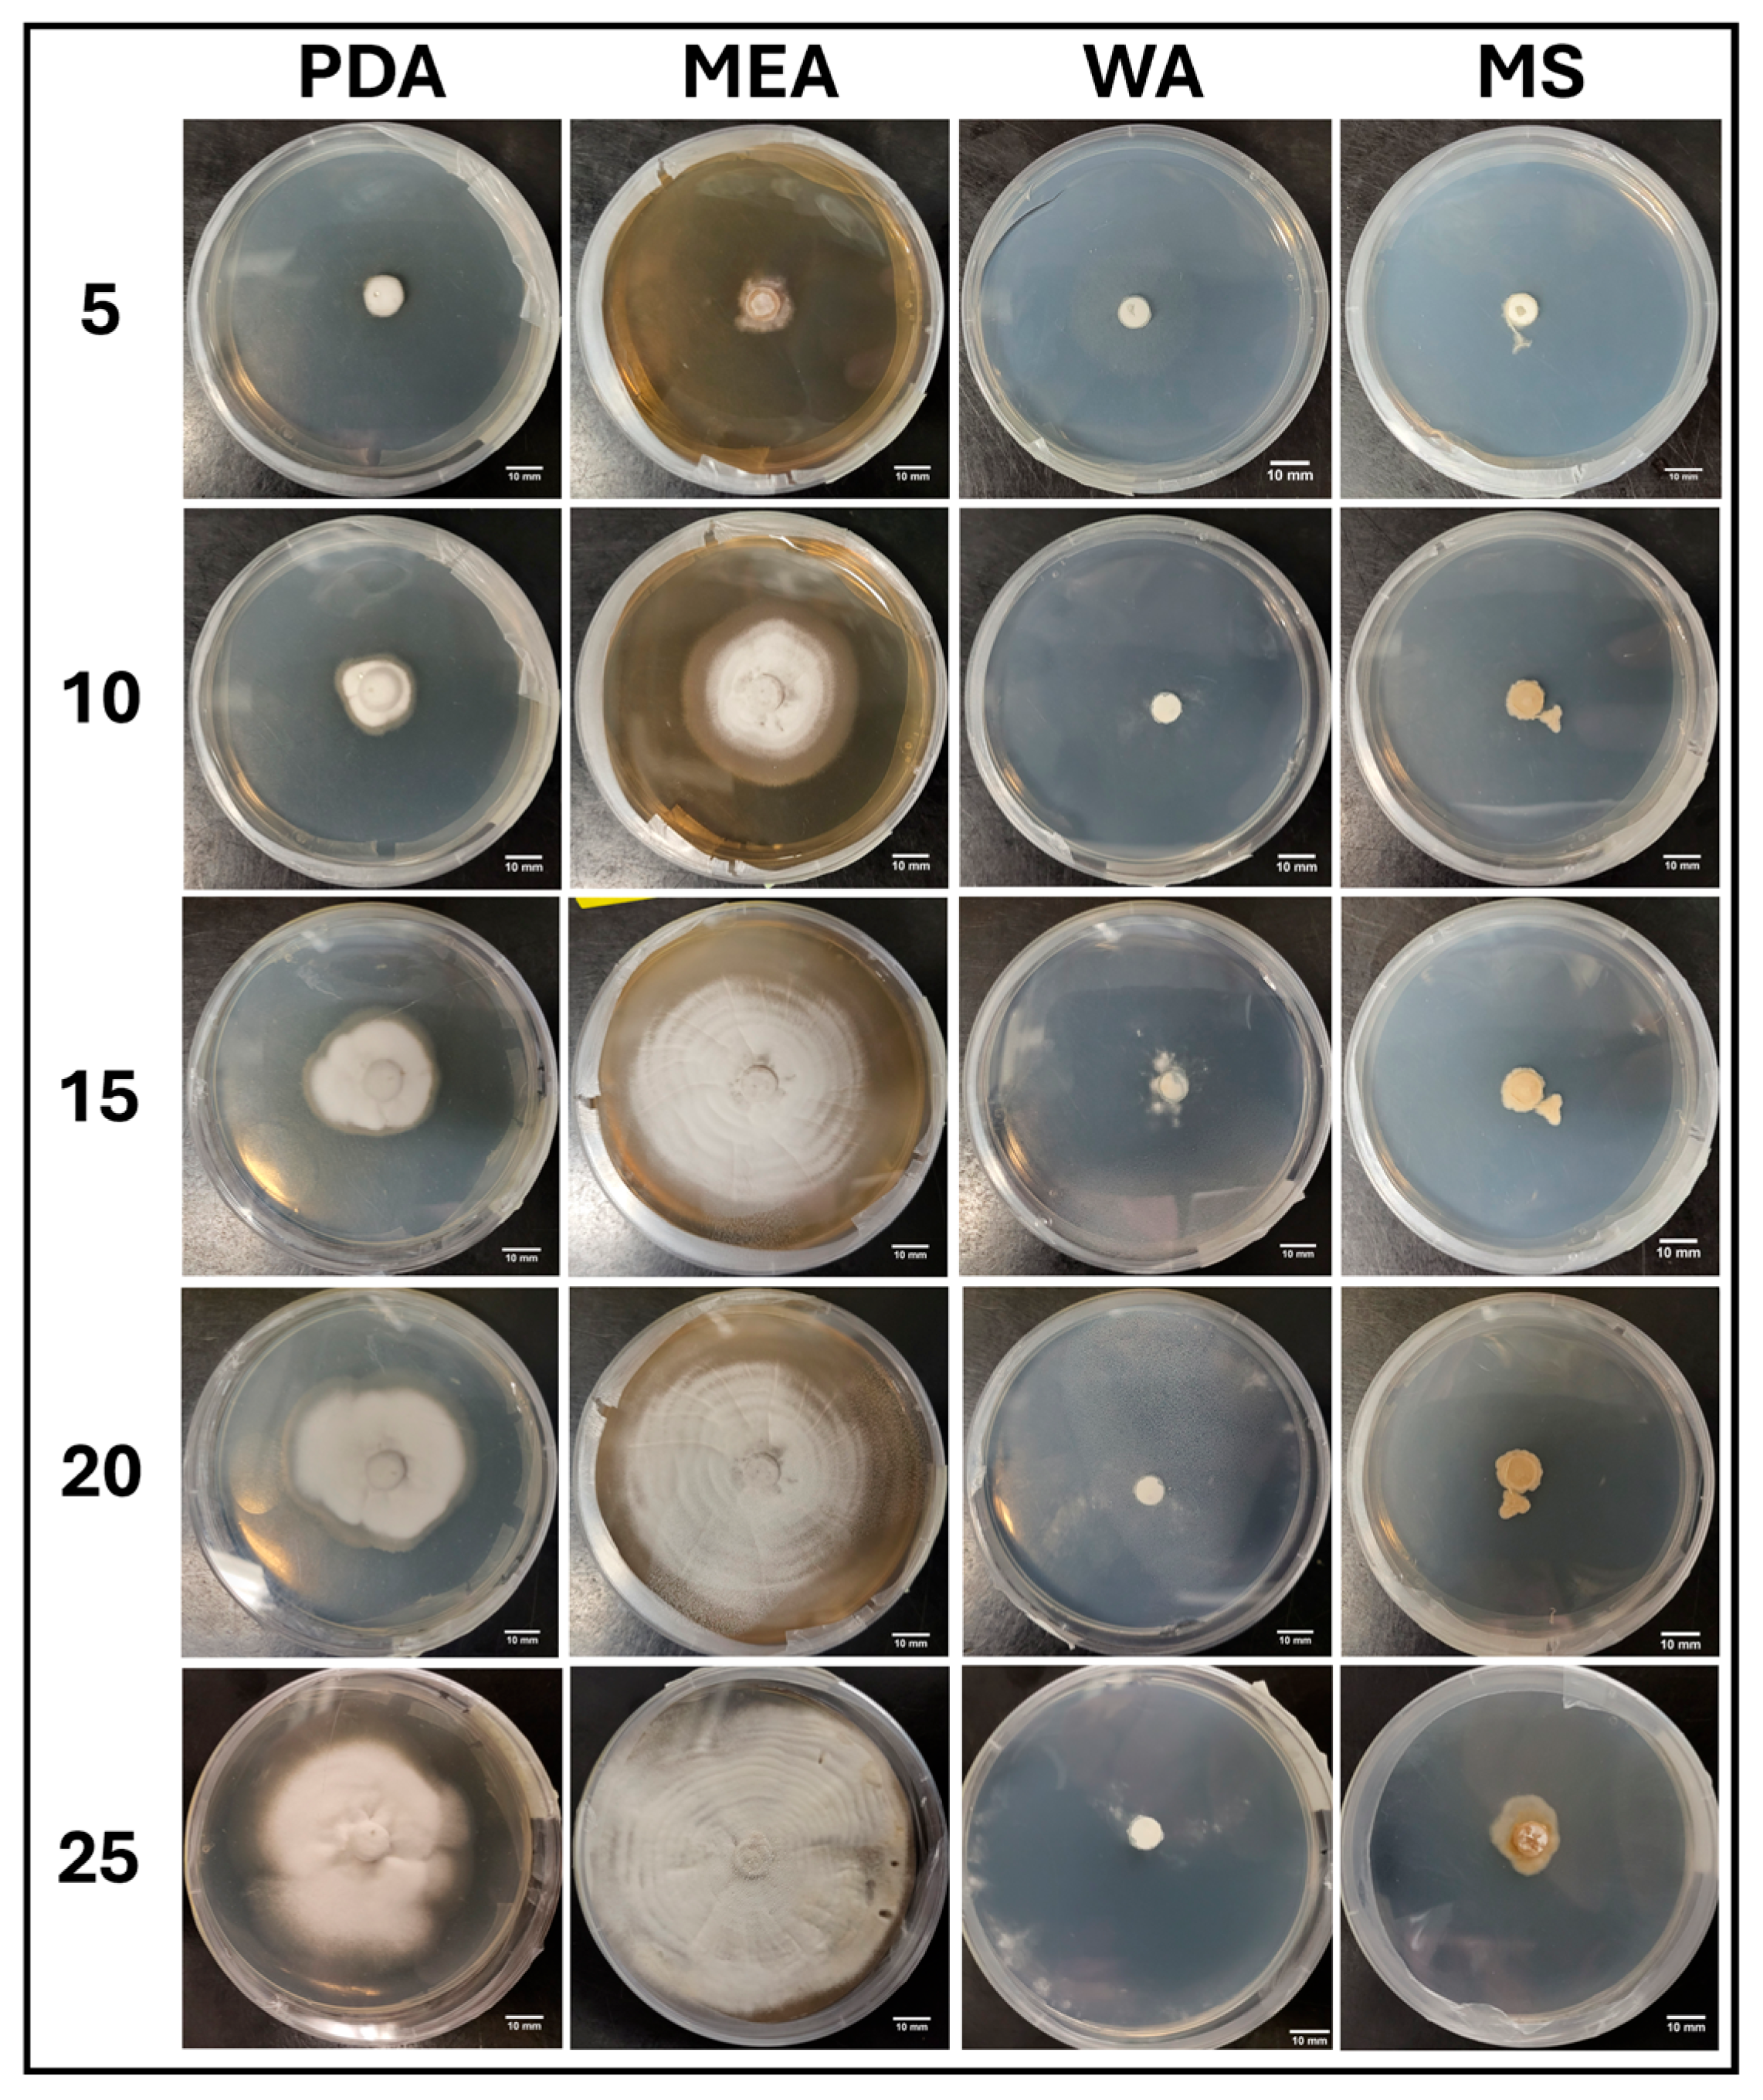
Jof 11 00450 g005
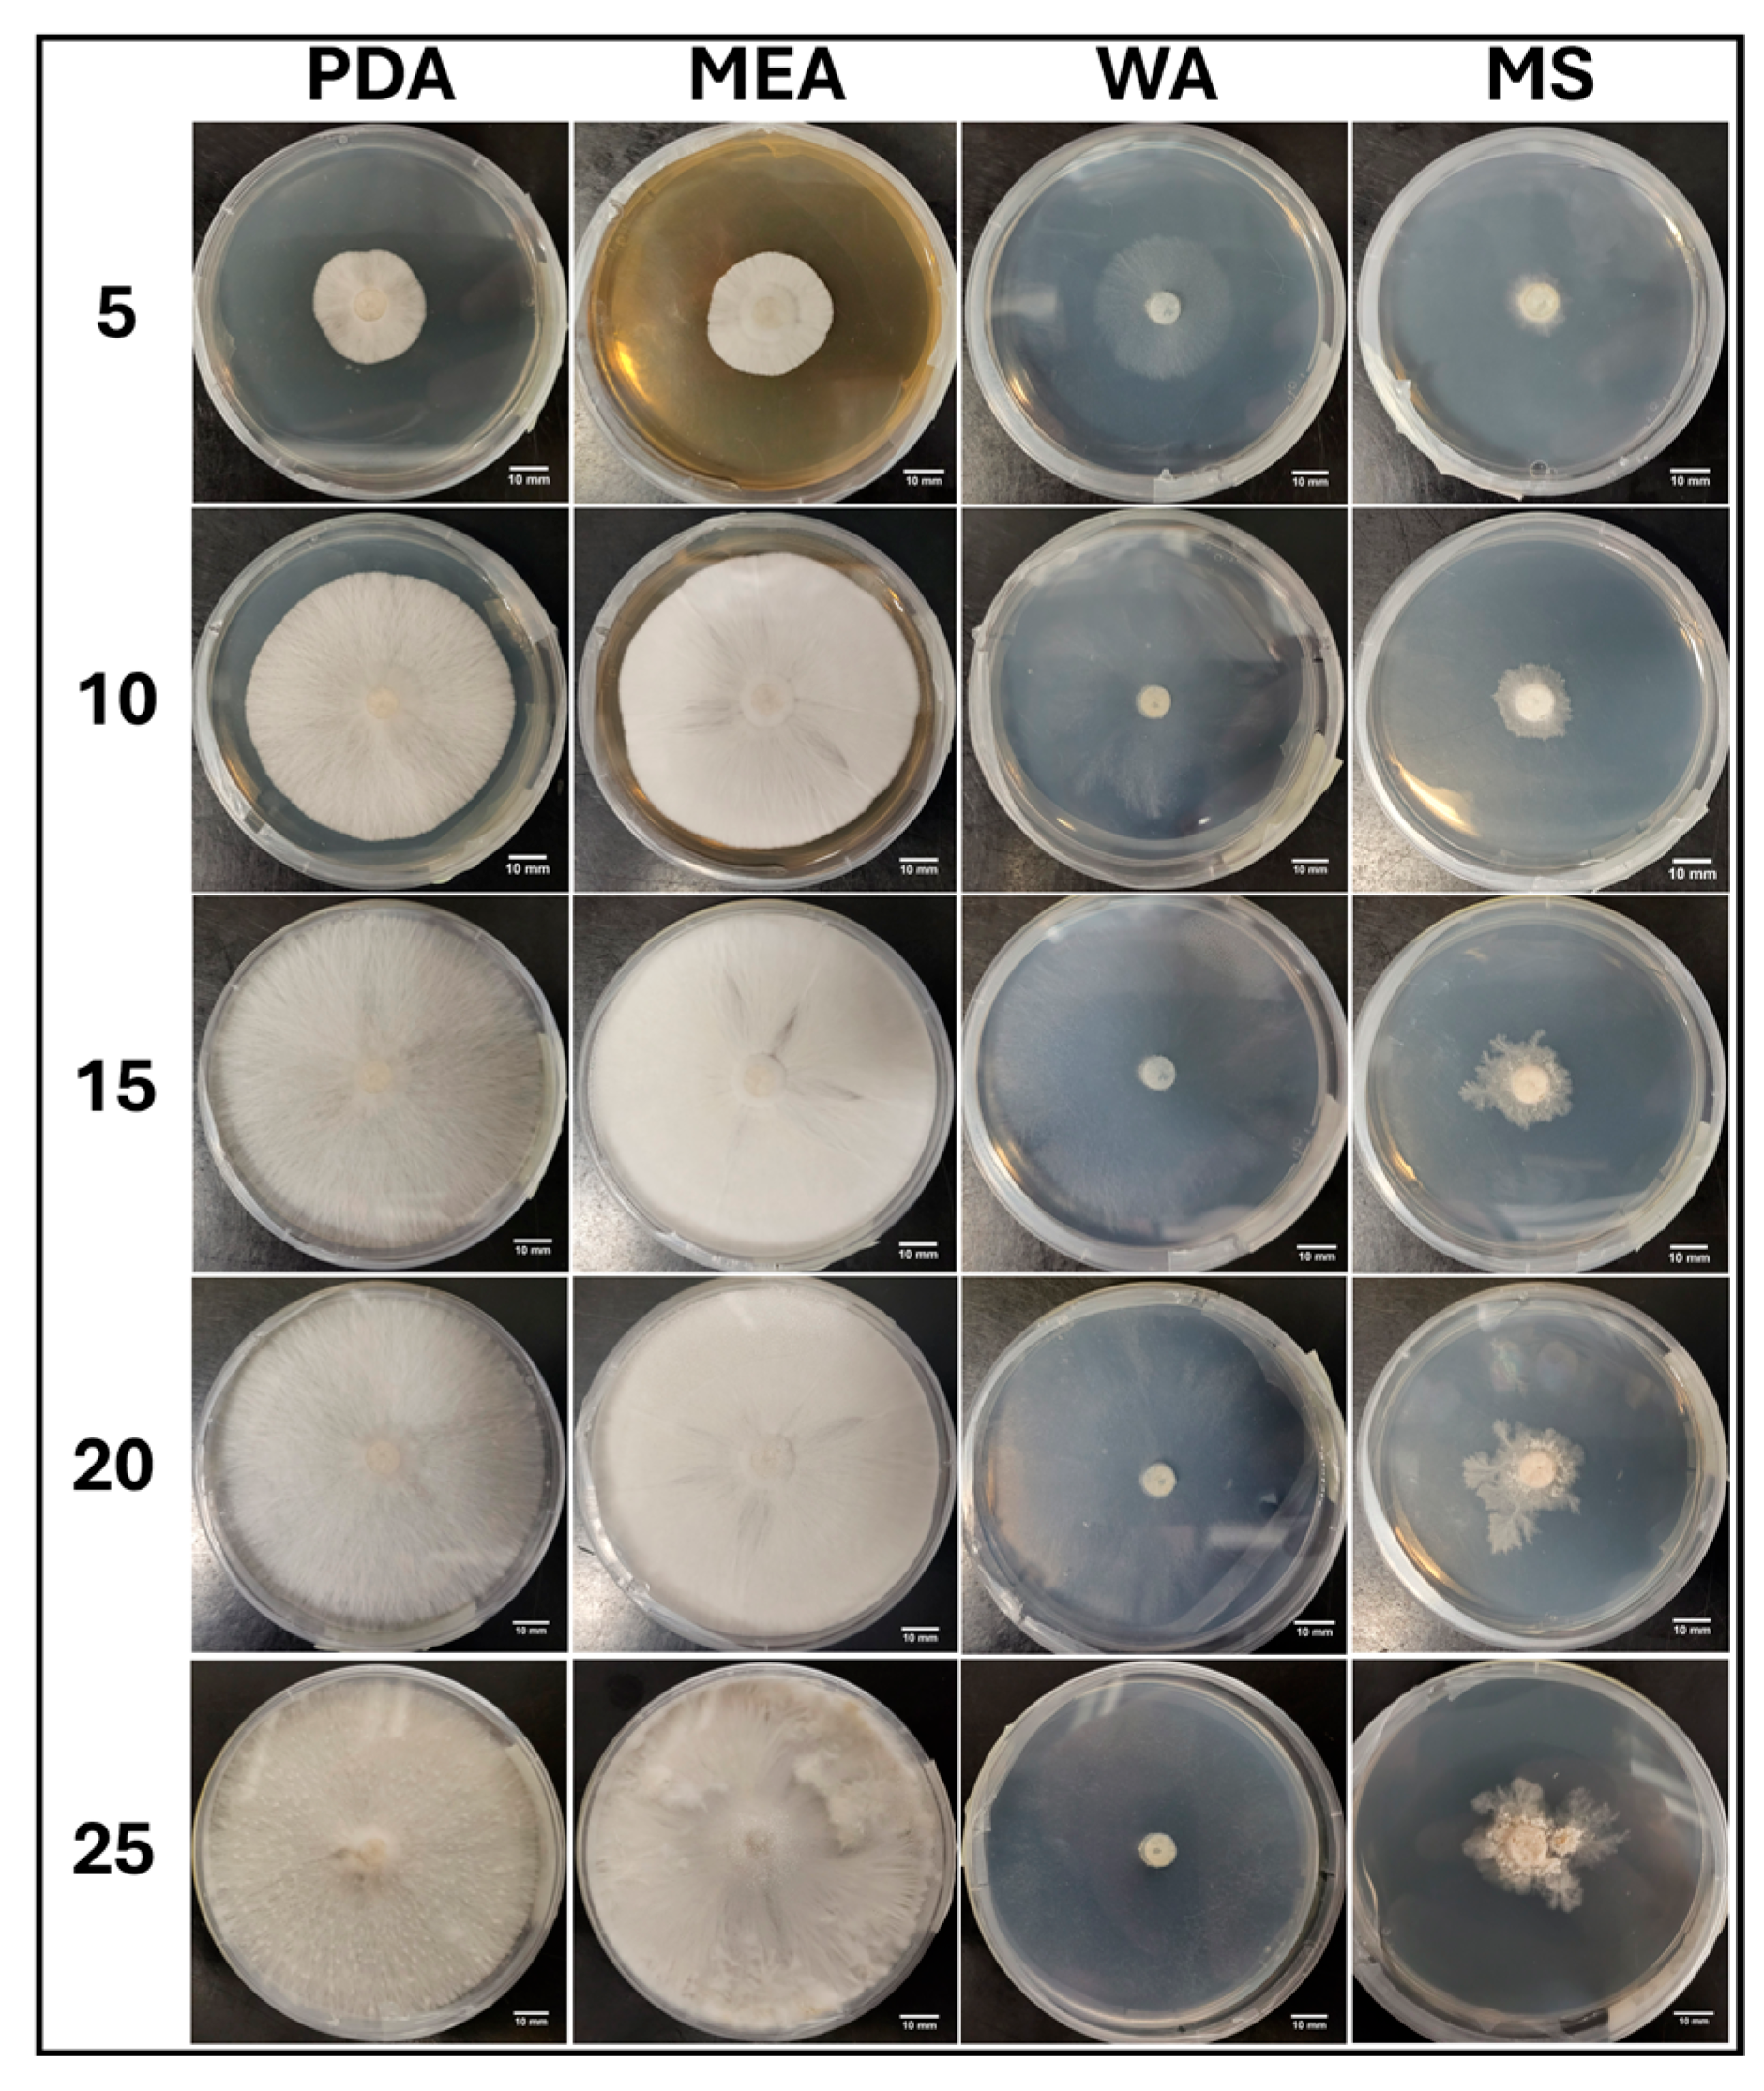
Jof 11 00450 g007
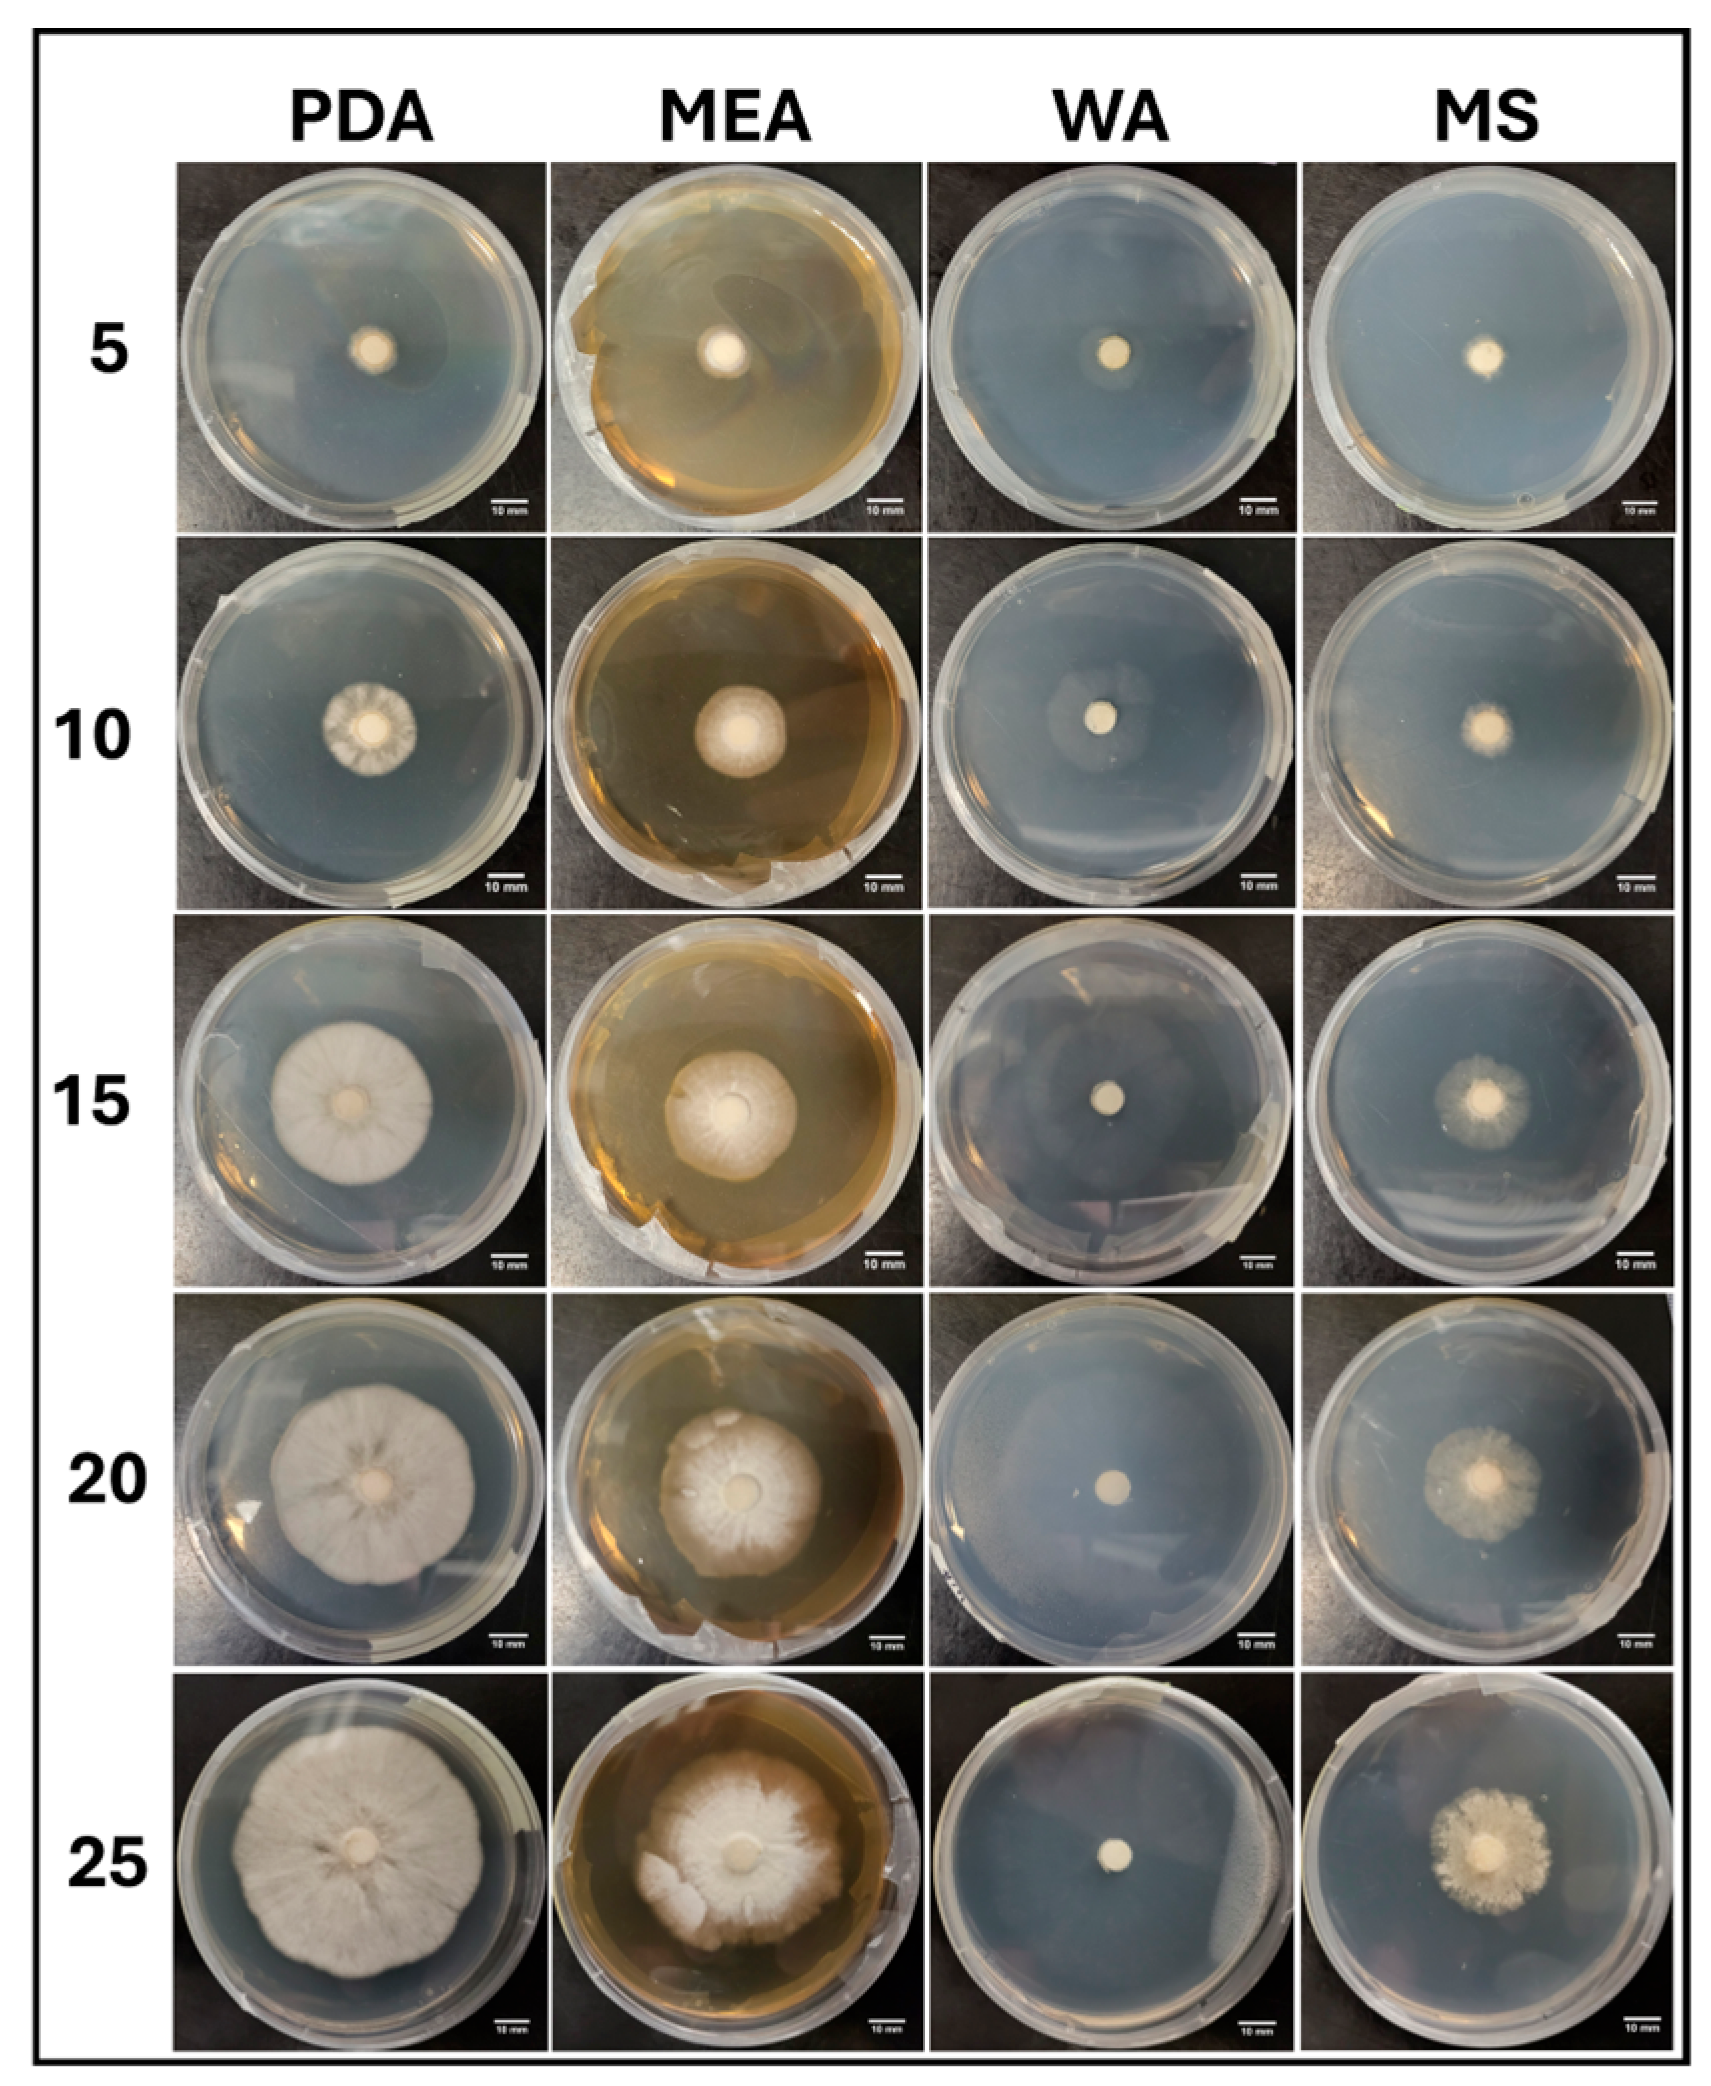
Jof 11 00450 g011
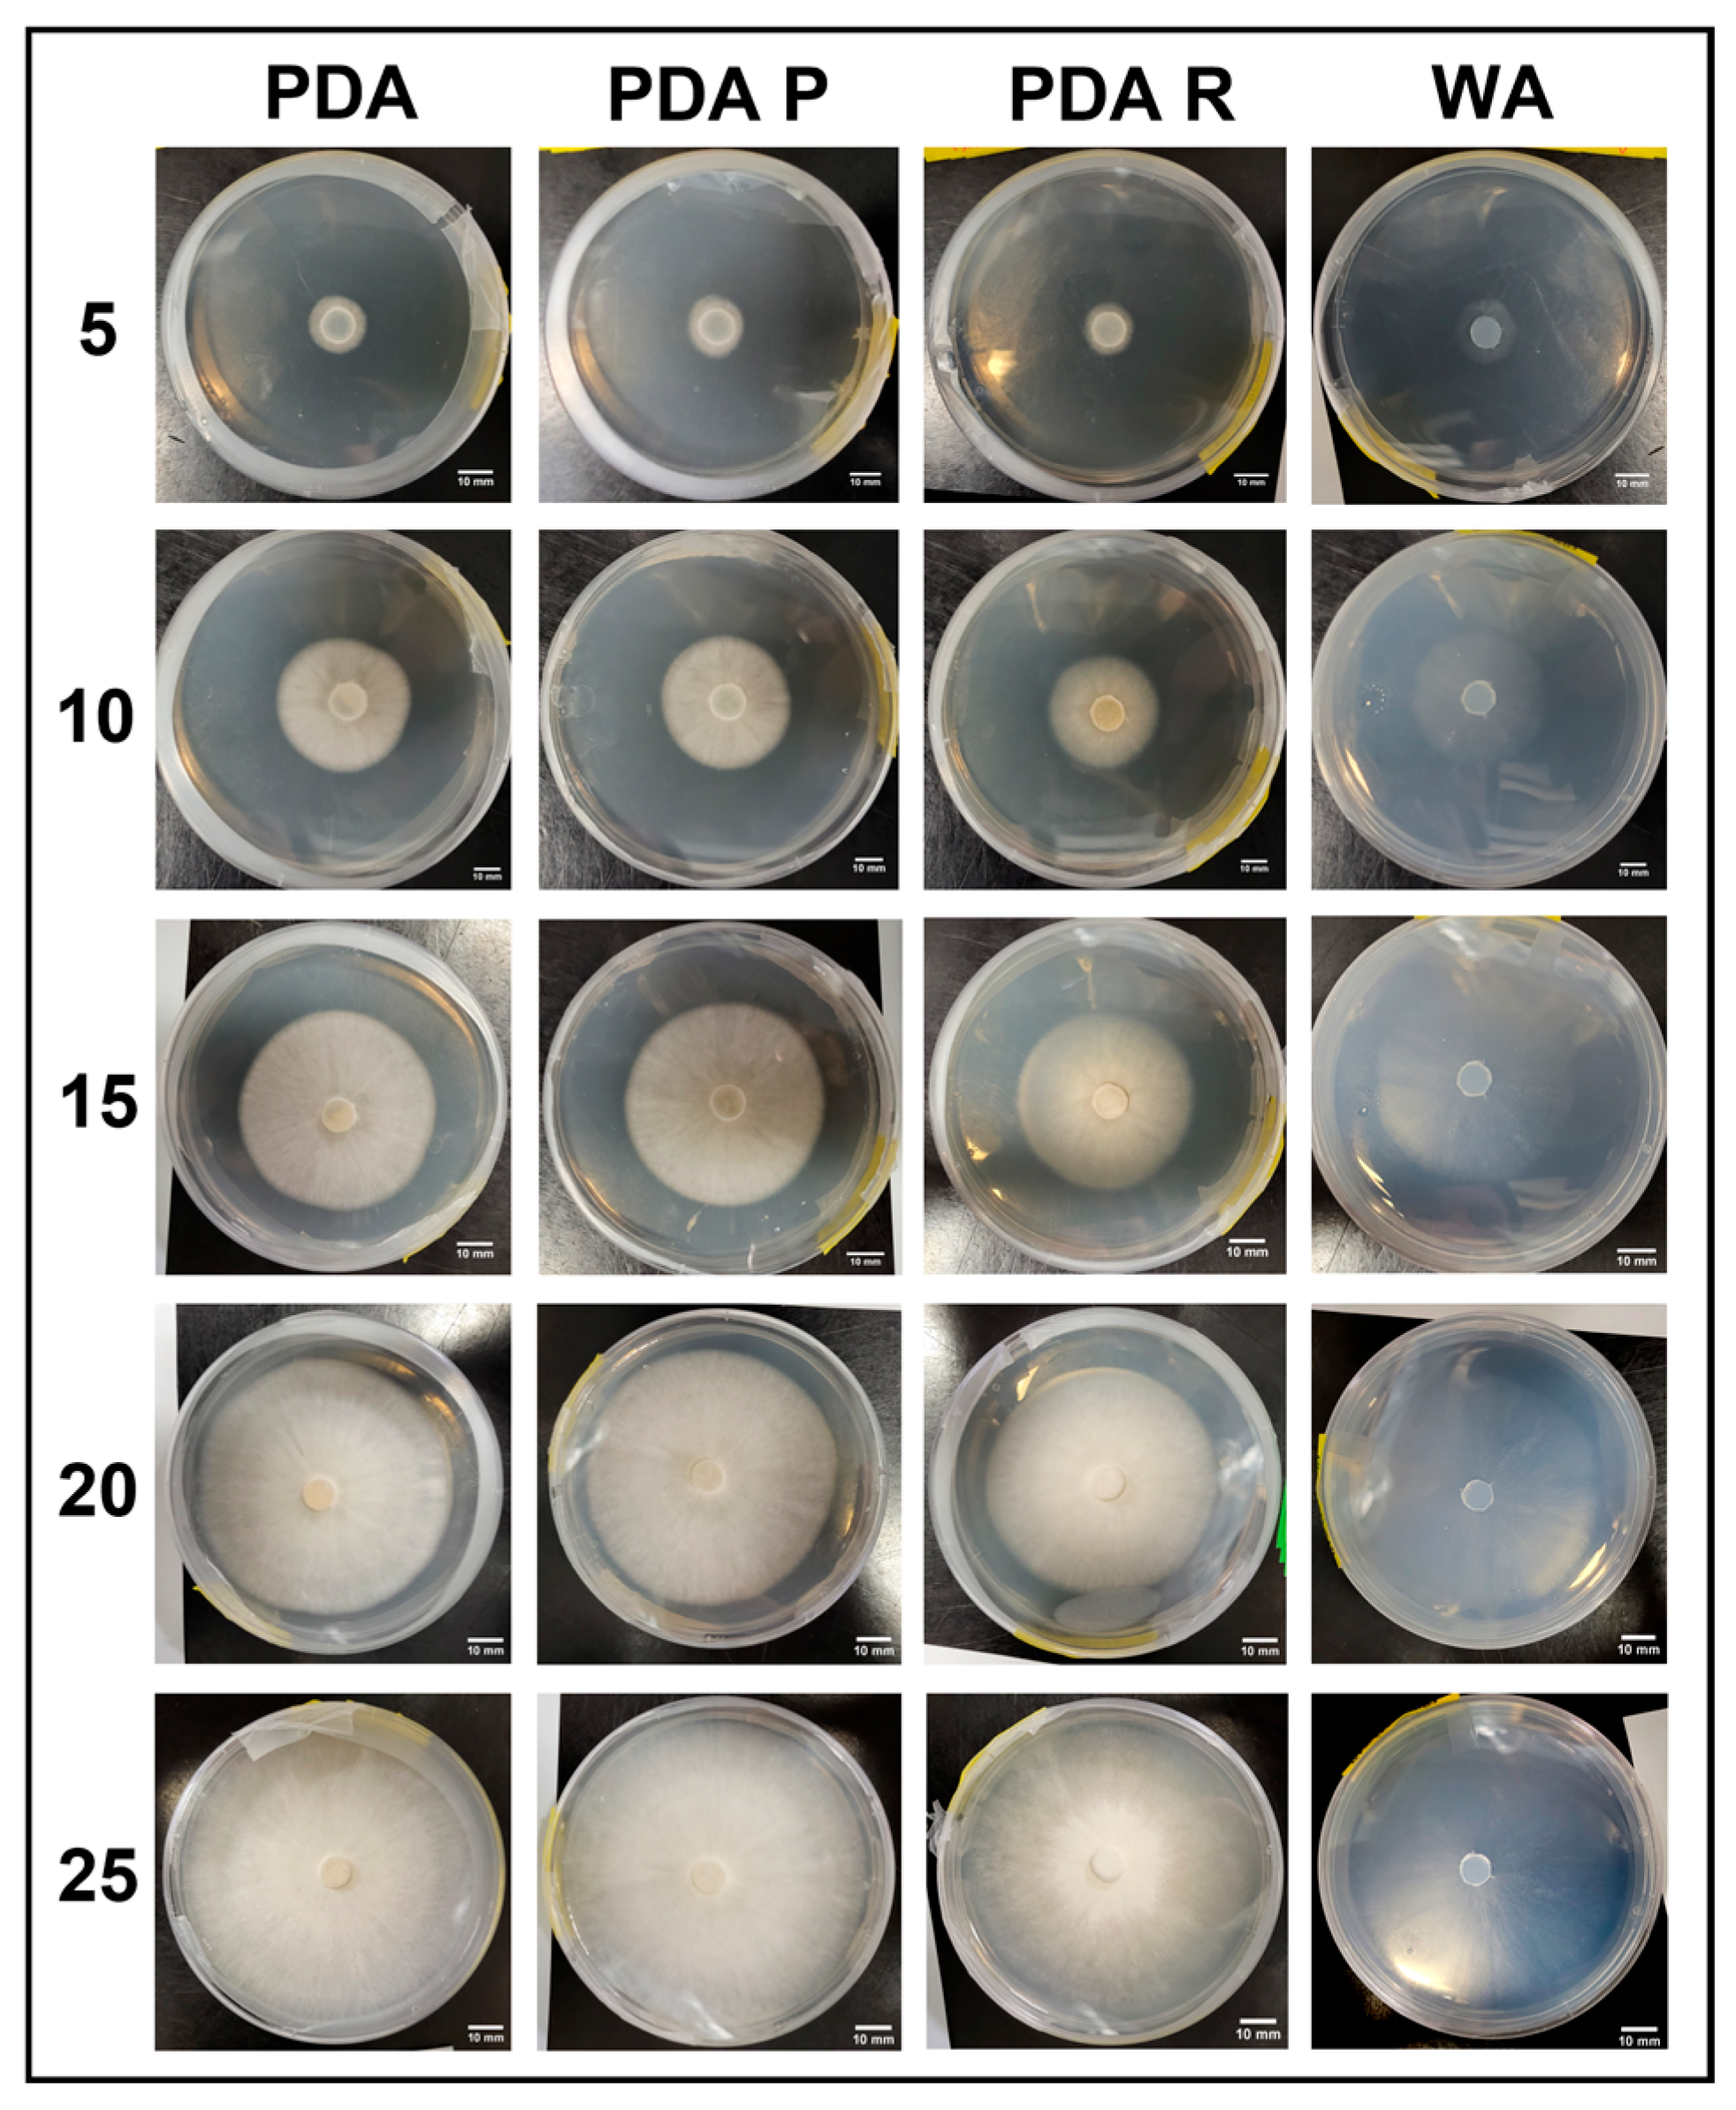
Jof 11 00450 g019
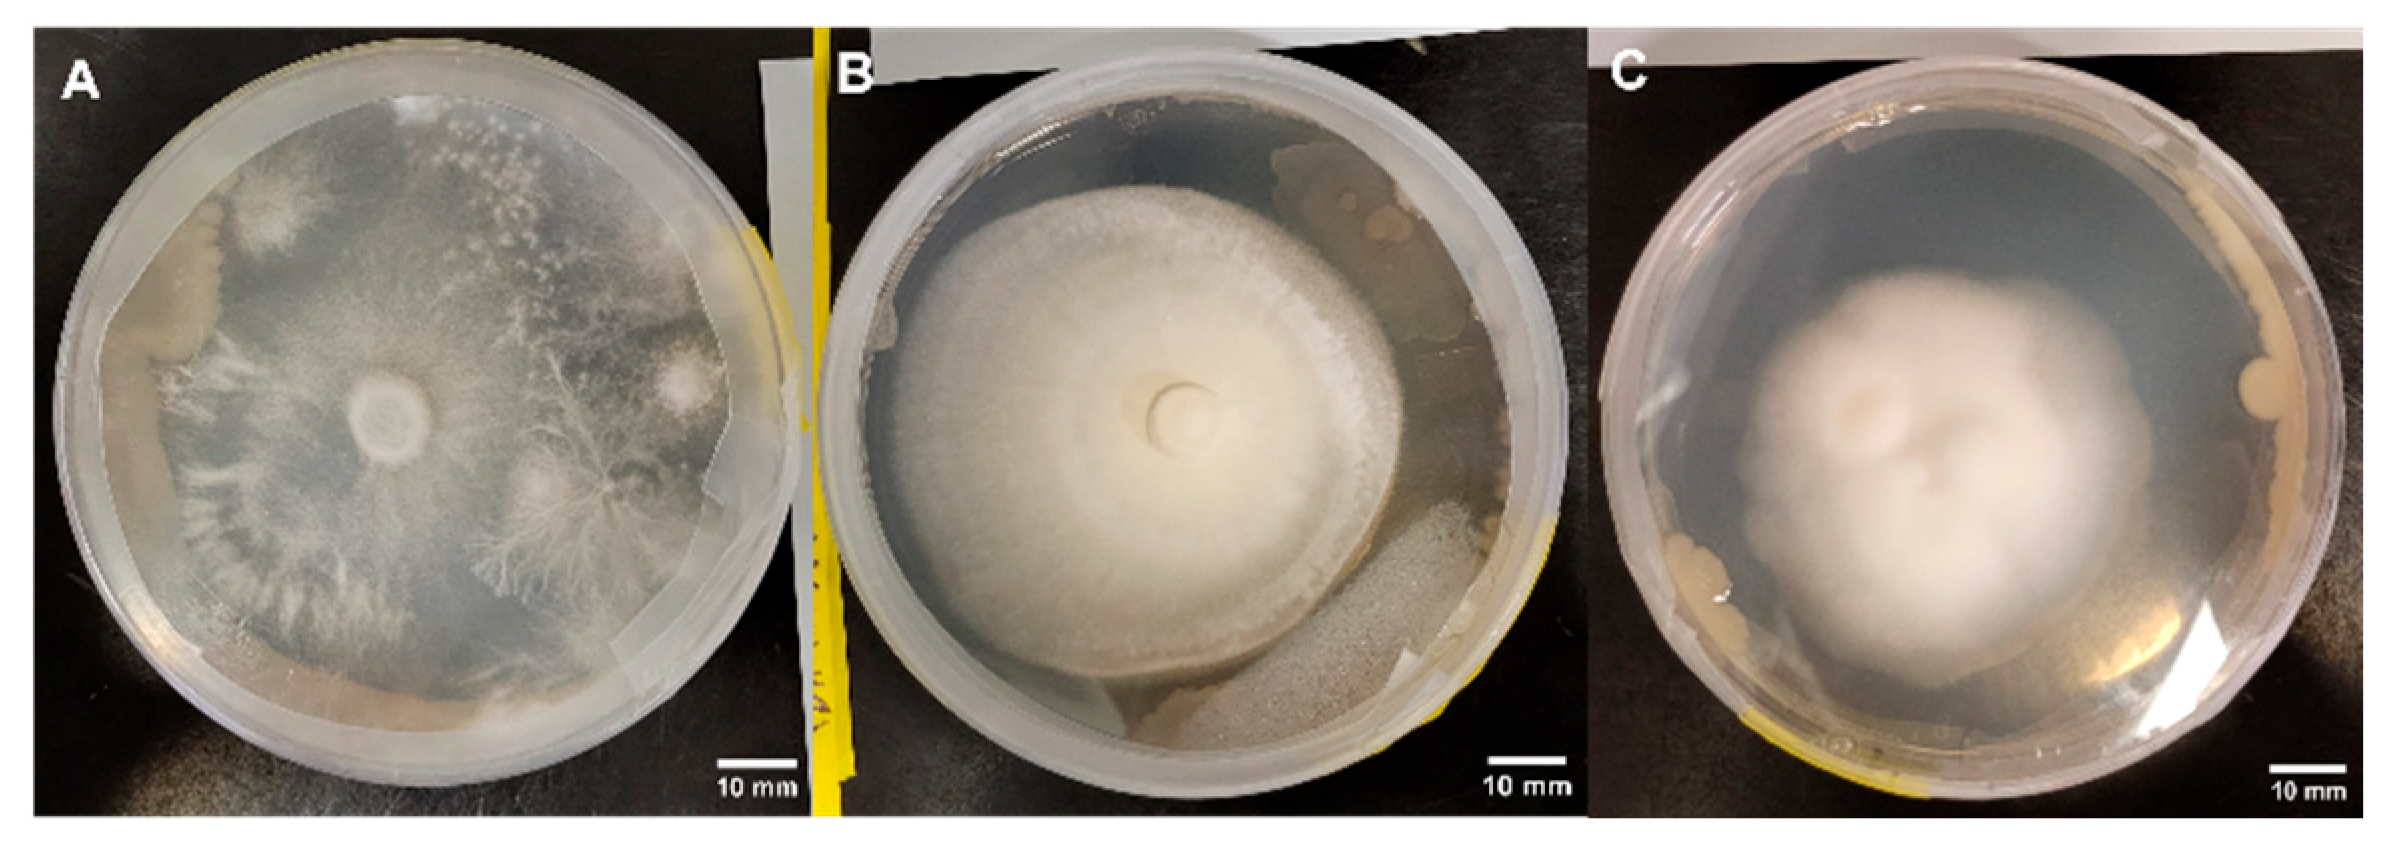
Jof 11 00450 g020

Mycelium Growth and Development of Psilocybe spp. Mother Cultures on Agar-Based Media
Abstract
1. Introduction
2. Materials and Methods
2.1. Fungal Material
2.2. Experimental Treatments and Media Preparation
2.3. Growth Assessment
2.4. Morphology Assessment
3. Results
3.1. Experimental Series 1
3.1.1. Growth Trends on Day 25
3.1.2. Growth Response 5-Day Trends of APE
3.1.3. Growth Response 5-Day Trends of B+
3.1.4. Growth Response 5-Day Trends of JMF
3.1.5. Growth Response 5-Day Trends of PA
3.1.6. Morphology Assessments
3.2. Experimental Series 2
3.2.1. Growth Trends on Day 25
3.2.2. Growth Response 5-Day Trends of APE
3.2.3. Growth Response 5-Day Trends of B+
3.2.4. Growth Response 5-Day Trends of JMF
3.2.5. Growth Response 5-Day Trends of PA
3.2.6. Morphology Assessments
3.3. Observations Related to Contamination
4. Discussion
5. Conclusions
Supplementary Materials
Author Contributions
Funding
Institutional Review Board Statement
Informed Consent Statement
Data Availability Statement
Acknowledgments
Conflicts of Interest
References
- Pepe, M.; Hesami, M.; De, K.A.; Perreault, M.L.; Hsiang, T.; Maxwell, A.; Jones, P. A journey with psychedelic mushrooms: From historical relevance to biology, cultivation, medicinal uses, biotechnology, and beyond. Biotechnol. Adv. 2023, 69, 108247. [Google Scholar] [CrossRef] [PubMed]
- Sommano, S.R.; Suksathan, R.; Sombat, T.; Seehanam, P.; Sirilun, S.; Ruksiriwanich, W.; Wangtueai, S.; Leksawasdi, N. Novel Perspective of Medicinal Mushroom Cultivations: A Review Case for ‘Magic’ Mushrooms. Agronomy 2022, 12, 3185. [Google Scholar] [CrossRef]
- Van Court, R.C.; Wiseman, M.S.; Meyer, K.W.; Ballhorn, D.J.; Amses, K.R.; Slot, J.C.; Dentinger, B.T.M.; Gari-bay-Orijel, R.; Uehling, J.K. Diversity, biology, and history of psilocybin-containing fungi: Suggestions for research and technological development. Fungal Biol. 2022, 126, 308–319. [Google Scholar] [CrossRef]
- Plotnik, L.; Gibbs, G.; Graham, T. Psilocybin Conspectus: Status, Production Methods, and Considerations. Int. J. Med. Mushrooms 2022, 24, 1–11. [Google Scholar] [CrossRef] [PubMed]
- Haukongo, K.N.; Horn, L. Effects of different substrates as medium for mushrooms cultivation. Acad. J. Food Res. 2021, 9, 32–37. [Google Scholar] [CrossRef]
- Bustillos, R.; Dulay, R.M.R.; Kalawa, S.P.; Reyes, R.G. Optimization of culture conditions for mycelial growth and basidiocarp production of Philippine strains of Panaeolus antillarium and Panaeolus cyanescens. Mycosphere 2014, 5, 398–404. [Google Scholar] [CrossRef]
- Zhu, Y.; Pan, J.; Qiu, J.; Guan, X. Optimization of Nutritional Requirements for Mycelial Growth and Sporulation of Entomogenous Fungus Aschersonia Aleyrodis Webber. Braz. J. Microbiol. 2008, 39, 770–775. [Google Scholar] [CrossRef]
- Ajdari, Z.; Ebrahimpour, A.; Abdul Manan, M.; Hamid, M.; Mohamad, R.; Ariff, A.B. Nutritional requirements for the improvement of growth and sporulation of several strains of Monascus purpureus on solid state cultivation. BioMed Res. Int. 2011, 2011, 487329. [Google Scholar] [CrossRef]
- Griffith, G.W.; Easton, G.L.; Detheridge, A.; Roderick, K.; Edwards, A.; Worgan, H.J.; Nicholson, J.; Perkins, W.T. Copper deficiency in potato dextrose agar causes reduced pigmentation in cultures of various fungi. FEMS Microbiol. Lett. 2007, 276, 165–171. [Google Scholar] [CrossRef]
- Black, W.D. A comparison of several media types and basic techniques used to assess outdoor airborne fungi in Melbourne, Australia. PLoS ONE 2020, 15, e0238901. [Google Scholar] [CrossRef]
- Mahadevan, K.; Shanmugasundaram, K. Comparative effect of different culture media on mycelial growth performance of Pleurotus sapidus. J. Pharmacogn. Phytochem. 2018, 7, 874–878. [Google Scholar]
- Ravimannan, N.; Arulanantham, R.; Pathmanathan, S.; Niranjan, K. Alternative culture media for fungal growth using different formulation of protein sources. Sch. Res. Libr. Ann. Biol. Res. 2014, 5, 36–39. [Google Scholar]
- Westphal, K.R.; Heidelbach, S.; Zeuner, E.J.; Riisgaard-Jensen, M.; Nielsen, M.E.; Vestergaard, S.Z.; Bekker, N.S.; Skovmark, J.; Olesen, C.K.; Thomsen, K.H.; et al. The effects of different potato dextrose agar media on secondary metabolite production in Fusarium. Int. J. Food Microbiol. 2021, 347, 109171. [Google Scholar] [CrossRef] [PubMed]
- Pradeep, F.S.; Begam, M.S.; Palaniswamy, M.; Pradeep, B.V. Influence of Culture Media on Growth and Pigment Production by Fusarium moniliforme KUMBF1201 Isolated from Paddy Field Soil. World Appl. Sci. J. 2013, 22, 70–77. [Google Scholar] [CrossRef]
- Almjalawi, B.S.A.; Chechan, R.A.; Al-Hadedee, L.T. Using food residues (potato peels) as an alternative to potato dextrose agar in the growth of edible food fungi. J. Appl. Nat. Sci. 2023, 15, 211–219. [Google Scholar] [CrossRef]
- Sholberg, P.L.; Ogawa, J.M.; Inouye, T.S. Nitrogen source corrects a potato-dextrose agar medium deficient in supporting mycelial growth of Monilinia spp. Plant Dis. 1981, 8, 649–651. [Google Scholar] [CrossRef]
- Srivastava, A.; SIngs, G.; Kumar, P.; Verma, P.K.; Rahmani, U.; Sharma, A.; Yadav, A. Studies on the effect of different trace elements and vitamins on mycelial growth of Shiitake mushroom (Lentinula edodes) (Berk.) Pegler. Pharma Innov. J. 2023, 8, 1526–1530. [Google Scholar]
- Liu, F.; Xiang, M.; Guo, Y.; Wu, X.; Lu, G.; Yang, Y.; Liu, X.; Chen, S.; Zhang, G.; Shi, W. Culture conditions and nutrition requirements for the mycelial growth of Isaria farinosa (Hypocreales: Cordycipitaceae) and the altitude effect on its growth and metabolome. Sci. Rep. 2018, 8, 15623. [Google Scholar] [CrossRef]
- Rueden, C.T.; Schindelin, J.; Hiner, M.C.; DeZonia, B.E.; Walter, A.E.; Arena, E.T.; Eliceiri, K.W. ImageJ2: ImageJ for the next generation of scientific image data. BMC Bioinform. 2017, 18, 529. [Google Scholar] [CrossRef]
- Wartchow, F.; Carvalho, A.S.; Sousa, M.C.A.; Cortez, V.G. Some coprophilous Psilocybe (Strophariaceae) from Pernambuco State, Northeast Brazil. Sitientibus Série Ciências Biológicas 2007, 7, 150–153. [Google Scholar] [CrossRef]
- Borovička, J.; Rockefeller, A.; Werner, P.G. Psilocybe allenii—A new bluing species from the Pacific Coast, USA. Czech Mycol. 2012, 64, 181–195. [Google Scholar] [CrossRef]
- Rahmani, U.; Patel, S.V. Assessment of different media and grain extract on mycelia growth of Shiitake mushroom Lentinula edodes (Berk.) Pegler. Pharma Innov. J. 2023, 7, 3706–3710. [Google Scholar] [CrossRef]
- Viegas, C.; Dias, M.; Carolino, E.; Sabino, R. Culture media and sampling collection method for Aspergillus spp. assessment: Tackling the gap between recommendations and the scientific evidence. Atmosphere 2021, 12, 23. [Google Scholar] [CrossRef]
- Nussbaum, N.; von Wyl, T.; Gandia, A.; Romanens, E.; Rühs, P.A.; Fischer, P. Impact of malt concentration in solid substrate on mycelial growth and network connectivity in Ganoderma species. Sci. Rep. 2023, 13, 1241–1246. [Google Scholar] [CrossRef]
- Harris, C.N.; Dickson, R.W.; Fisher, P.R.; Jackson, B.E.; Poleatewich, A.M. Evaluating peat substrates amended with pine wood fiber for nitrogen immobilization and effects on plant performance with container-grown petunia. HortTechnology 2020, 30, 107–116. [Google Scholar] [CrossRef]
- Macias-Corral, M.A.; Cueto-Wong, J.A.; Morán-Martínez, J.; Reynoso-Cuevas, L. Effect of different initial C/N ratio of cow manure and straw on microbial quality of compost. Int. J. Recycl. Org. Waste Agric. 2019, 8, 357–365. [Google Scholar] [CrossRef]
- Boyle, D. Nutritional Factors Limiting the Growth of Lentinula Edodes and Other White-Rot Fungi in Wood. Soil Biol. Biochem. 1998, 30, 817–823. [Google Scholar] [CrossRef]
- Aditya; Neeraj; Jarial, K.; Jarial, K.; Bhatia, J. Comprehensive review on oyster mushroom species (Agaricomycetes): Morphology, nutrition, cultivation and future aspects. Heliyon 2024, 10, e26539. [Google Scholar] [CrossRef]
- Wang, W.; Zhao, J.; Zhang, K.; Wang, Z.; Ma, J.; Yang, Q.; Lin, C. Transcriptome Analysis of Aureobasidium pullulans YQ65 Grown on Yeast Extract Peptone Glucose and Potato Dextrose Agar Media and Quantification of Their Effects on Pullulan Production. Foods 2024, 13, 3619. [Google Scholar] [CrossRef]
- Calaça, F.J.S.; Araújo, J.C.; de Melo e Silva-Neto, C.; Xavier-Santos, S. A microcosmic experimental overview of durability and nutritional aspects of feces to dung-inhabiting fungi development. Sci. Rep. 2024, 14, 30334. [Google Scholar] [CrossRef]
- Henríquez, L.B.F.; Rentas, M.F.; Zafalon, R.V.A.; Perini, M.P.; Marchi, P.H.; Rodrigues, R.B.A.; Vendramini, T.H.A.; Gomes, C.O.M.; de Carvalho Balieiro, J.C.; Brunetto, M.A. Effects of Malt Extract on Nutritional and Functional Aspects in Healthy Adult Dogs. Fermentation 2023, 9, 870. [Google Scholar] [CrossRef]
- Kinoka, M. Potato and potato peels: A comprehensive review on potato peels nutritional composition, bioactive compounds and its application in the food industry. Pharma Innov. J. 2023, 12, 2217–2225. [Google Scholar]
- Subramanian, N.K.; White, P.J.; Broadley, M.R.; Ramsay, G. The three-dimensional distribution of minerals in potato tubers. Ann. Bot. 2011, 107, 681–691. [Google Scholar] [CrossRef] [PubMed]
- Smilanick, J.L.; Henson, D.J. Minimum gaseous sulphur dioxide concentrations and exposure periods to control Botrytis cinerea. Crop Prot. 1992, 11, 535–540. [Google Scholar] [CrossRef]
- Onofre, R.B.; Gadoury, D.M.; Peres, N.A. High Efficacy and Low Risk of Phytotoxicity of Sulfur in the Suppression of Strawberry Powdery Mildew. Plant Health Prog. 2021, 22, 101–107. [Google Scholar] [CrossRef]
- Boumaaza, B.; Benkhelifa, M.; Belkhoudja, M. Effects of two salts compounds on mycelial growth, sporulation, and spore germination of six isolates of Botrytis cinereain the Western North of Algeria. Int. J. Microbiol. 2015, 2015, 572626. [Google Scholar] [CrossRef]
- Rahman, A.M.; Bedsole, C.O.; Akib, Y.M.; Hamilton, J.; Rahman, T.T.; Shaw, B.D.; Pei, Z. Effects of Sodium Alginate and Calcium Chloride on Fungal Growth and Viability in Biomass-Fungi Composite Materials Used for 3D Printing. Biomimetics 2024, 9, 251. [Google Scholar] [CrossRef]
- Schoder, K.A.; Krümpel, J.; Müller, J.; Lemmer, A. Effects of Environmental and Nutritional Conditions on Mycelium Growth of Three Basidiomycota. Mycobiology 2024, 52, 124–134. [Google Scholar] [CrossRef]
- Budzyńska, S.; Siwulski, M.; Magdziak, Z.; Budka, A.; Gąsecka, M.; Kalač, P.; Rzymski, P.; Niedzielski, P.; Mleczek, M. Influence of iron addition (Alone or with calcium) to elements biofortification and antioxidants in Pholiota nameko. Plants 2021, 10, 2275. [Google Scholar] [CrossRef]
- Kalaw, S.; Alfonso, D.; Dulay, R.; De Leon, A.; Undan, J.; Reyes, R. Optimization of culture conditions for secondary mycelial growth of wild macrofungi from selected areas in Central Luzon, Philippines. Curr. Res. Environ. Appl. Mycol. 2016, 6, 277–287. [Google Scholar] [CrossRef]
- Hesami, M.; Pepe, M.; Alizadeh, M.; Rakei, A.; Baiton, A.; Phineas Jones, A.M. Recent advances in cannabis biotechnology. Ind. Crop Prod. 2020, 158, 113026. [Google Scholar] [CrossRef]
- Noorhazira, S.; Nuraini, S.M.A.; Laila, N.; Kharul, A.M.A.R. The effect of different nutrient media on in vitro shoot and root proliferation of Vanilla planifolia Jacks. ex Andrews. Afr. J. Biotechnol. 2018, 17, 1241–1246. [Google Scholar] [CrossRef]
- Zafur, M.A.; Munsur, A.; Al Munsur, M.; Miah, A.; Rahman, M.H.; Rahman, M.M.; Yahia, A. Effect of Varieties and Media on Mycelial Growth and Substrate on Spawn Production of Oyster Mushroom. Bang-Ladesh Res. Publ. J. 2012, 7, 361–366. [Google Scholar]
- Nasim, G.; Hameed, S.; Bajwa, R.; Afzal, M.; Mian, S. Effect of Three Different Culture Media on Mycelial Growth of Oyster and Chinese Mushrooms. J. Biol. Sci. 2001, 1, 1130–1133. [Google Scholar] [CrossRef]
- Aleklett, K.; Ohlsson, P.; Bengtsson, M.; Hammer, E.C. Fungal foraging behaviour and hyphal space exploration in micro-structured Soil Chips. ISME J. 2021, 15, 1782–1793. [Google Scholar] [CrossRef]
- Orban, A.; Jerschow, J.J.; Birk, F.; Suarez, C.; Schnell, S.; Rühl, M. Effect of bacterial volatiles on the mycelial growth of mushrooms. Microbiol. Res. 2023, 266, 127250. [Google Scholar] [CrossRef]
- Shamugam, S.; Kertesz, M.A. Bacterial interactions with the mycelium of the cultivated edible mushrooms Agaricus bisporus and Pleurotus ostreatus. J. Appl. Microbiol. 2023, 134, lxac018. [Google Scholar] [CrossRef] [PubMed]
- Yafetto, L. The structure of mycelial cords and rhizomorphs of fungi: A minireview. Mycosphere 2018, 9, 984–998. [Google Scholar] [CrossRef]
- Akinyele, J.B.; Fakoya, S.; Adetuyi, C.F. Anti-Growth Factors Associated with Pleurotus ostreatus in a Submerged Liquid Fermentation. Malays. J. Microbiol. 2012, 8, 135–140. [Google Scholar] [CrossRef]

| Media | Details | Dextrose | Potato |
|---|---|---|---|
| Potato Dextrose Agar (PDA) | Peeled potatoes boiled for 30 min., broth used in media. | 20 g/L | 200 g/L |
| Potato Dextrose Agar Peel (PDA P) | Unpeeled potatoes boiled for 30 min., broth used in media. | 20 g/L | 200 g/L |
| Potato Dextrose Agar Powder (PDA R) | As directed by the supplier, 24 g/L was used. | 0 | 0 |
| Malt Extract Agar (MEA) | As directed by the supplier, 20 g/L was used. | 0 | 0 |
| Murashige and Skoog (MS) | As directed by the supplier, 4.33 g/L was used. | 20 g/L | 0 |
| Water Agar (WA) | Distilled water and agar. | 0 | 0 |
| Genotype | Mean % Colonization on Day 25 | Mean Surface Area Colonized on Day 25 (mm2) | ||||||
|---|---|---|---|---|---|---|---|---|
| WA | PDA | MEA | MS | WA | PDA | MEA | MS | |
| APE | 100% | 30.5% | 95.8% | 4.0% | 5674.50 a | 1729.91 b | 5436.25 a | 225.16 c |
| B+ | 100% | 100% | 100% | 15.7% | 5674.50 a | 5674.50 a | 5674.50 a | 890.17 b |
| JMF | 95.6% | 55.4% | 64.2% | 9.2% | 5426.73 a | 2180.84 b | 3644.23 c | 523.29 d |
| PA | 61.8% | 69.7% | 47.8% | 14.2% | 3504.34 a | 3957.89 a | 2711.10 b | 802.90 c |
| Genotype | % Morphology Occurrence | ||
|---|---|---|---|
| WA | PDA | MEA | |
| APE | 100% 1 | 75% 2 25% 3 | 50% 2 50% 3 |
| B+ | 100% 1 | 75% 3 25% 2 | 75% 3 25% 2 |
| JMF | 100% 1 | 100% 3 | 100% 3 |
| PA | 100% 1 | 100% 3 | 100% 2 |
| Media | Correlation Assessment | ||
|---|---|---|---|
| PCC | R2 | p | |
| PDA | 0.22 | 0.05 | 0.41 |
| MEA | 0.28 | 0.08 | 0.29 |
| Genotype | Mean % Colonization on Day 25 | Mean Surface Area Colonized on Day 25 (mm2) | ||||||
|---|---|---|---|---|---|---|---|---|
| PDA P | PDA | WA | PDA R | PDA P | PDA | WA | PDA R | |
| APE | 83.7% | 72.3% | 95% | 0% | 4751.91 a | 4102.86 a | 5390.62 a | 0 b |
| B+ | 100% | 100% | 97.8% | 100% | 5674.50 a | 5674.50 a | 5548.06 a | 5674.50 a |
| JMF | 59.5% | 49.1% | 97.5% | 32.0% | 3373.50 a | 2786.94 a | 5534.74 b | 1817.44 c |
| PA | 96.4% | 95.2% | 81.3% | 82.5% | 5468.25 a | 5399.45 a | 4612.11 b | 4678.37 b |
| Genotype | % Morphology Occurrence per Treatment | |||
|---|---|---|---|---|
| PDA P | PDA | WA | PDA R | |
| APE | 100% 2 | 100% 2 | 100% 1 | 100% 0 |
| B+ | 100% 3 | 100% 3 | 100% 1 | 100% 3 |
| JMF | 75% 2 25% 3 | 67% 2 33% 3 | 100% 1 | 50% 2 50% 3 |
| PA | 100% 3 | 100% 3 | 100% 1 | 67% 3 33% 2 |
| Media | Correlation Assessment | ||
|---|---|---|---|
| PCC | R2 | p | |
| PDA P | 0.53 | 0.28 | 0.03 |
| PDA | 0.41 | 0.17 | 0.15 |
| PDA R | 0.82 | 0.69 | 0.0001 |
Disclaimer/Publisher’s Note: The statements, opinions and data contained in all publications are solely those of the individual author(s) and contributor(s) and not of MDPI and/or the editor(s). MDPI and/or the editor(s) disclaim responsibility for any injury to people or property resulting from any ideas, methods, instructions or products referred to in the content. |
© 2025 by the authors. Licensee MDPI, Basel, Switzerland. This article is an open access article distributed under the terms and conditions of the Creative Commons Attribution (CC BY) license (https://creativecommons.org/licenses/by/4.0/).
Share and Cite
Pepe, M.; Hesami, M.; Fleishmann, L.; Hsiang, T.; Jones, A.M.P. Mycelium Growth and Development of Psilocybe spp. Mother Cultures on Agar-Based Media. J. Fungi 2025, 11, 450. https://doi.org/10.3390/jof11060450
Pepe M, Hesami M, Fleishmann L, Hsiang T, Jones AMP. Mycelium Growth and Development of Psilocybe spp. Mother Cultures on Agar-Based Media. Journal of Fungi. 2025; 11(6):450. https://doi.org/10.3390/jof11060450
Chicago/Turabian StylePepe, Marco, Mohsen Hesami, Livia Fleishmann, Tom Hsiang, and Andrew Maxwell Phineas Jones. 2025. "Mycelium Growth and Development of Psilocybe spp. Mother Cultures on Agar-Based Media" Journal of Fungi 11, no. 6: 450. https://doi.org/10.3390/jof11060450
APA StylePepe, M., Hesami, M., Fleishmann, L., Hsiang, T., & Jones, A. M. P. (2025). Mycelium Growth and Development of Psilocybe spp. Mother Cultures on Agar-Based Media. Journal of Fungi, 11(6), 450. https://doi.org/10.3390/jof11060450

